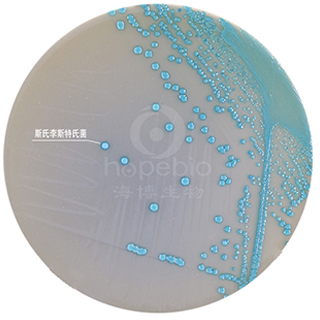
产品细节图片3

相关产品推荐更多 >
万千商家帮你免费找货
0 人在求购买到急需产品
- 详细信息
- 文献和实验
- 技术资料
- 保存条件:
请置于阴凉干燥处保存
- 保质期:
三年
- 英文名:
Listeria Chromogenic Medium
- 库存:
100
- 供应商:
青岛海博生物
- 规格:
10个/包
成份(g/L)
基础培养基:
| 营养物质 | 70.0 |
| 显色剂 | 1.0 |
| pH 7.2±0.2 25℃ | |
李斯特氏菌添加剂6.0g、李斯特氏菌抑菌剂1 1ml*5支、李斯特氏菌抑菌剂2 1ml*5支 (已配套,无需另购)
此配方可以进行改良或增加营养成份以获得最佳的结果。
操作步骤
1、按SN标准、GB标准、FDA标准、ISO标准或其它标准制备样品液;
2、把样品液加入李氏增菌肉汤(LB1、LB2)中增菌;或把样品液和Half-Fraser增菌液按照 1:10 的比例混匀,30℃ 培养 24 小时;或其它增菌液中增菌培养;
3、取一环增菌液划线接种到李斯特氏菌显色培养基上,37℃ 培养 24-48 小时。
质量控制
1、外观
平板呈不透明乳白色培养基。
2、微生物试验
在37℃培养24-48小时:
| 质控菌株 |
ATCC |
生长情况 |
菌落颜色 |
不透明环 |
| 单增李斯特氏菌 |
27853 |
+++ |
蓝色 |
+ |
| 绵羊李斯特氏菌 |
CICC21663 |
+++ |
蓝色 |
+ |
| 西尔李斯特氏菌 |
CICC21617 |
+++ |
蓝色 |
- |
| 金黄色葡萄球菌 |
25923 |
++ |
黄色 |
- |
| 大肠杆菌 |
25922 |
- |
- |
- |
| 沙门氏菌 |
14028 |
- |
- |
- |
典型特征
单增李斯特氏菌 37℃ 培养 24-28 小时,平板上出现蓝色菌落,菌落周围有一不透明环。绵羊李斯特氏菌 37℃ 培养 48 小时,平板上出现蓝色菌落,菌落周围有一不透明环。西尔李斯特氏菌 37℃ 培养 24-48 小时,平板上出现蓝色菌落,菌落周围没有不透明环。在食品检测中绵羊李斯特氏菌非常少见。
注意
此培养基仅供实验室使用。
查看我公司所有显色平板菌落特征,请点击:
显色平板菌落特征
|
|
|
| 李斯特氏菌显色培养基 单增李斯特氏菌ATCC19115 |
李斯特氏菌显色培养基 绵羊李斯特氏菌 |
|
|
|
| 李斯特氏菌显色培养基 斯氏李斯特氏菌 |
|
李斯特氏菌显色培养基的微生物灵敏度试验:
按标签用法制备培养基,接种以下质控菌株,放置37℃需氧培养24-48小时。
风险提示:丁香通仅作为第三方平台,为商家信息发布提供平台空间。用户咨询产品时请注意保护个人信息及财产安全,合理判断,谨慎选购商品,商家和用户对交易行为负责。对于医疗器械类产品,请先查证核实企业经营资质和医疗器械产品注册证情况。
文献和实验作者:张淑红,吴清平,张菊梅 作者单位:广东环凯微生物科技有限公司,广州510070;2.广东省微生物研究所广东省菌种保藏与应用重点实验室,广州510070 [摘要] 目的:研究显色培养基对单核细胞增生李斯特菌的检测效果,探讨建立新型快速检测方法。方法:检测按国标GB4789—33程序进行。结果:人工污染样品和实际样品检测中,显色培养基CHROMagar Listeria和HKListeria与传统平板OXA和MMA可以达到相同的检测限和灵敏度,且具有更高
菌种活化:干粉标准菌株 标准贮备菌株 工作菌株; 1.1 金黄色葡萄球菌、大肠埃希氏菌、铜绿假单胞菌、枯草芽孢杆菌标准菌株: 挑取部分干粉溶解于0.9% 无菌氯化钠溶液中,划线接种于营养琼脂平板上,36℃±1℃ 培养18-24 小时。并观察菌落形态。 a. 金黄色葡萄球菌:菌落凸起,圆形,不透明; b. 大肠埃希氏菌:菌落稍凸,圆形,湿润,乳白色; c. 铜绿假单胞菌:菌落扁平,圆形,边缘不整齐,光滑湿润,可产生蓝绿或黄绿色素; d. 枯草芽孢杆菌: 表面粗糙不透明
前两天遇到一SS平板上可疑沙门氏菌,挑取到沙门氏显色平板上,为紫红色菌落,符合。挑双糖管K/A-及综合发酵管(葡萄糖+甘露醇+蔗糖-动力+产气+H2S+IND-尿素酶—),生化反应完全符合沙门氏。血清凝集A-F多价不凝集(或者说是极其微弱的凝集),常见的O1,O4,O9,O7(均为国产血清)均不凝集。想起疾控老师的经验:凝集不好的放室温(不要放冰箱)1到2天后可能凝集的要好些,综合发酵管1比双糖管的菌凝集更好,再不好传代后再凝集。放置一天后,A-F多价血清一分钟后可见凝集,比前一天
技术资料暂无技术资料 索取技术资料